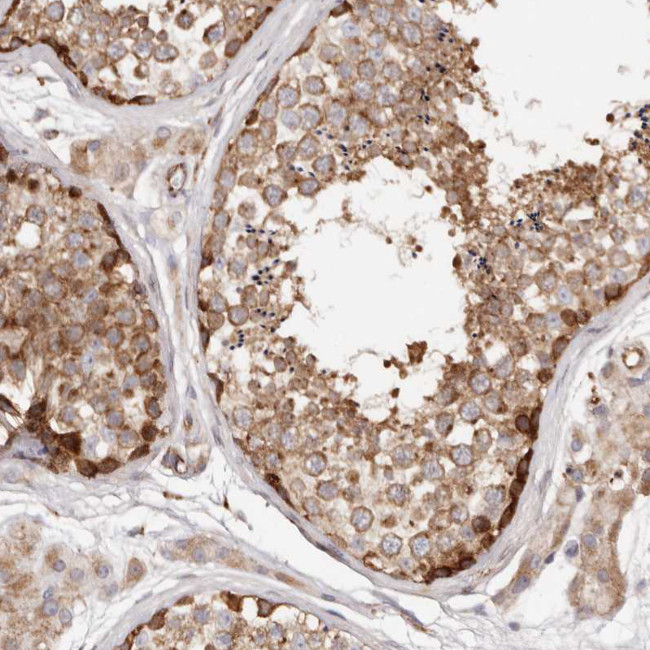
PTPN22 Antibody in Immunohistochemistry (Paraffin) (IHC (P))

Search
Invitrogen
PTPN22 Polyclonal Antibody
{{$productOrderCtrl.translations['antibody.pdp.commerceCard.promotion.promotions']}}
{{$productOrderCtrl.translations['antibody.pdp.commerceCard.promotion.viewpromo']}}
{{$productOrderCtrl.translations['antibody.pdp.commerceCard.promotion.promocode']}}: {{promo.promoCode}} {{promo.promoTitle}} {{promo.promoDescription}}. {{$productOrderCtrl.translations['antibody.pdp.commerceCard.promotion.learnmore']}}
产品信息
PA5-53047
种属反应
宿主/亚型
分类
类型
抗原
偶联物
形式
浓度
规格
纯化类型
保存液
内含物
保存条件
运输条件
RRID
产品详细信息
Immunogen sequence: SLLNQESAVL ATAPRIDDEI PPPLPVRTPE SFIVVEEAGE FSPNVPKSLS SAVKVKIGTS LEWGGTSEPK KFDDSVILRP SKSVKLRSPK SELHQDRSSP PPPLPERTLE SFFLADEDCM Q
Highest antigen sequence identity to the following orthologs: Mouse - 69%, Rat - 64%.
靶标信息
The protein tyrosine phosphatase PTPN22 (PTP22, LYP, PEP, formerly PTPN8) is a genetic variant that confers risk of developing diverse human autoimmune diseases such as type 1 diabetes and rheumatoid arthritis. The minor allele of a missense SNP in PTPN22 encodes a hematopoietic-specific protein tyrosine phosphatase also known as "Lyp." The risk allele is present in about 17% of Caucasian individuals from the general population and in approximately 28% of Caucasian individuals with rheumatoid arthritis; it is thought to disrupt the P1 proline-rich motif that is important for interaction with the Src homology-3 (SH3) domain of CSK (cytoplasmic tyrosine kinase), potentially altering the normal functions of these proteins as negative regulators of T cell activation. The interaction between CSK and PTPN22 is highly specific and it is speculated that PTPN22 may be an effector and/or regulator of CSK in T cells and other hematopoietic cells.
仅用于科研。不用于诊断过程。未经明确授权不得转售。
篇参考文献 (0)
生物信息学
蛋白别名: Hematopoietic cell protein-tyrosine phosphatase 70Z-PEP; Lymphoid phosphatase; lymphoid-specific protein tyrosine phosphatase; LyP; LYP3; PEP; PEST-domain phosphatase; protein tyrosine phosphatase, non-receptor type 22 (lymphoid); protein tyrosine phosphatase, non-receptor type 8; PTPN22.8; tyrosine-phosphatase; Tyrosine-protein phosphatase non-receptor type 22; unnamed protein product
基因别名: LYP; LYP1; LYP2; PEP; PTPN22; PTPN22.5; PTPN22.6; PTPN8
UniProt ID: (Human) Q9Y2R2
Entrez Gene ID: (Human) 26191